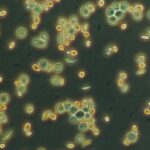

Programme à venir
La régionale de Nancy Metz passe la frontière et nous propose de nous inscrire à la sortie à la Bourse fossiles et minéraux à Saint-Marie-aux-Mines le samedi 28 juin 2025
Programme :
10h : Le rendez-vous est prévu à sur l’un des parkings.
L’entrée entre 8 et 12 € par personne (suivant l’effectif) sera prise en charge par l’APBG. https://my.weezevent.com/mineral-gem-2025
13h30 : déjeuner à la Ferme auberge Graine Johé au Col des Bagenelles Le bonhomme 03 89 47 51 55
Lien pour s’inscrire ici
Date limite d’inscription fixée au vendredi 20 juin (nécessité de réserver les restaurant et les billets d’entrée à la Bourse)
En préparation certainement pour l’automne 2025, une journée autour des levures et leurs applications. Un TP sera organisé sur une demi-journée à l’IUT par Jérôme Carrayrou, chef du département de Génie Biologique de l’IUT Louis Pasteur à Schiltigheim, la journée se poursuivra par une visite de la Brasserie Perle avec dégustation de leurs produits.
Pour pouvoir participer à ces sorties vous devez être membres de l’APBG .

